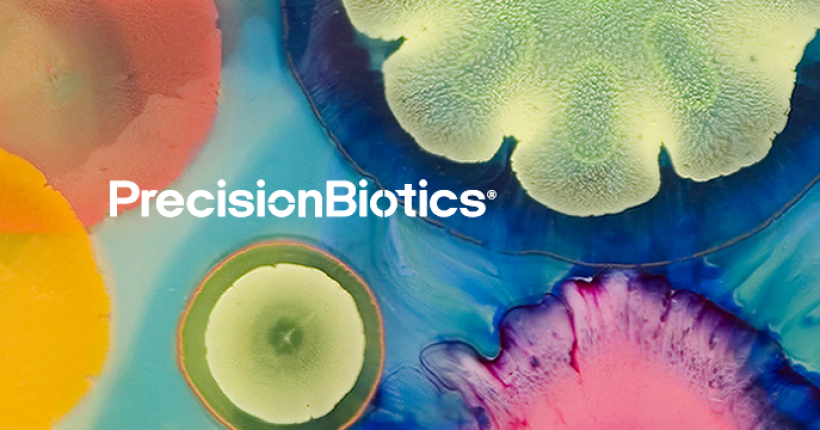
PB logo

The Content Marketing Team has been invaluable to Bensons for Beds from day one. Their writers provide top-quality content, even with the strictest of deadlines. I’m delighted to continue to work with The Content Marketing Team and always look forward to receiving their fantastic content for every project assigned.
Denise Morgan, SEO Content Lead
Bensons for Beds is Britain’s largest bed retailer specialising in beds, mattresses and bedroom furniture.
These self styled Sleep Experts have been “putting your Sleep Wellness® at the heart of everything we do for over 70 years.” Our brief was to support them with content that would both engage and inform the reader as well as improve Bensons for Bed’s organic search performance.
Creating engaging content designed to inform
With an impressive range of beds, mattresses and other bedroom furniture to learn about, it was important to understand the key features of Bensons for Bed’s products and how these features might benefit their customers.
Using a brand voice that doesn’t take itself too seriously but is absolutely serious about its products, we were briefed to generate upbeat, warm and humorous content which is both relatable and informative.
Long form content creation optimised for search
Working closely with the Content and SEO Team, we created content for Product Landing Pages (PLPs), Product Description Pages (PDPs) and FAQs.
We also crafted long form blog content for the Sleep Hub, on topics as diverse as ‘10 tips for hosting your kids sleepover’, ‘Bedroom Décor From the 1920s to the 2020s’ and ‘Will a memory foam mattress make me too hot in bed?’
As always, keyword research was critical to ensuring that our output matched search intent, so that the resulting content had the highest possible chance of reaching its intended audience.
Content enhancement to improve organic search performance
As well as generating content from scratch, The Content Marketing Team worked to enhance some of the existing content on the Bensons for Beds website, creating longer form articles which expanded on themes in greater depth, complete with evidenced based research.